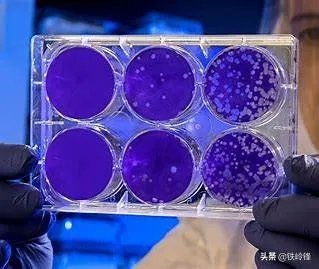
美国新增确诊减少了

美国的新增确诊人数,突然从35,000人下降到了26,000人,一下子下降了9000人。如果是其他国家出现这种情况,可能就意味着拐点要出现了。但这种情况发生在欧美国家,就不能作为判断出现拐点的依据了。
这种情况其实在欧洲国家也已经出现过了。此前在意大利就曾经出现过这样的情况,周六和周日的数据突然下降,让人们都以为意大利疫情的拐点马上就要出现了。可是到了周一又突然增加上去了,让人白高兴了一场。
为什么会出现这种情况呢?其实原因很简单。您周末的时候,负责检测的医疗机构和疾控都要休息了,这也就意味着这些国家的检测能力在周末的时候会突然下降,从而导致周末的新增确诊人数突然下降。而到周一的时候又会突然增加,这是因为周一上班之后周末积累的检测都会完成。

特朗普一直说美国第一,现在美国确实已经第一了。美国的累计确诊人数已经超过了30万人,但仍然看不到任何缓解的迹象,而且还在继续增加。更加让人感到不寒而栗的是,美国的检测数据中阳性比例特别高,纽约州一直持续维持在30%以上。
这是因为美国的检测仍然是以检测重症为主,轻症大多数居家隔离,或者是因为检测的门槛设置的比较高,即使出现了新冠肺炎的典型症状,如果症状比较轻微,也是无法及时得到检测的。即便是纽约州检测比较积极,其实也是一样的主要检测重症。大多数州的检测政策要比纽约州更加消极,轻症和无症状患者基本上无法得到检测。

按照特朗普的疫情医学顾问福奇的估计,美国的累计确诊人数将会达到100万人。即使按照目前相对比较乐观的估计,美国的累计确认人数已经达到50万人。所以现在就断言美国已经出现拐点,还为时过早。按照美国目前的检测能力,每天都新增确诊两三万人,可能在只需要一个星期,美国的累计确认人数就会超过50万人。
不过美国目前确诊之后的政策也很宽松,重症留在医院治疗,轻症只能回家隔离。按照目前公认的新冠肺炎疫情的轻重症比例,80%的患者都是轻症。但这些轻症患者是有能力传染其他人的,不把轻症患者集中隔离,疫情扩散的趋势就难以遏制住,疫情就会继续蔓延。
你说的这个情况是这样的:美国在前天(4月4日)的新增确诊是34970人,而在昨天(4月5日)的新增确诊是26674人。也就是说,美国的疫情正是爆发的高峰之时,怎么新确诊的病例一下子会减少1万人呢?因此,这样的数据结果让外界质疑美国的新诊确诊病例统计会不会有什么“猫腻”?润友分析认为,美国的新诊确诊病例一下子直降1万人,无非就是这么两个原因:
第一、就是美国从前天(4月4日)开始放慢了检测的速度,减少了感染人员的检测数量。据美国媒体报道,在4月3日之前,美国每天的检测人数大约为10万人左右,在这排查检测的感染人群中,有30%左右(即3万左右)的人确诊。这就意味着美国的感染率达到了30%以上。而从4月4日开始可能是由于检测试剂盒不足或有别的什么不让外界知晓的原因,而放慢了检测的速度,减少了检测人员的数量。因此,就出现了当日新增直降1万的情况。
第二、就是特郎普团队为了稳定民心、稳定股市、减少经济损失而采取的一种“速减”手段。因为,特总认为:“无论疫情多么严重,人们必须尽快上班。”在这种思想的支配下,特总团队就在每日的新增确诊上采取了“速减”措施。


全世界就美国的新型冠状病毒疫情是最为严重,美国已经连续三天,每天以三万例感染患者的速度在增长。说三天的时间,美国感染人数从20万直接跳到了30万。截止到4月6日12:00,美国的确诊病例是337620例,死亡人数是9643人。而美国新增感染人数达到了27827人,这相比较昨天的35000的感染人数有了一定幅度的回落。按照美国对外公布的数据来看,美国的确是出现了感染人数有所下降的态势。

不过有一点问题就是,即使美国的新增感染人数有所下降,但是美国庞大的基数和每天新增感染人数都是一个令人震惊的数字。而目前美国也只进行了167万人的核酸检测,就已经确诊了,其中33万人被感染,这个比例实在是太高了。美国拥有3.3亿人口,如果按照这样的比例检测下去,那么恐怕美国的感染人数还会呈现爆炸式的增长。毕竟美国的疫情已经在内部扩散,具体扩散到何种程度?目前谁都不好预料。

按照美国哥伦比亚大学的研究人员通过数学模型对美国新冠疫情发展进行了预测。美国疫情峰值最早也要到5月份才能到来,峰值日新增病例可达到50万。如果把传染率降低50%,美国未来2个月感染人数也将达到65万。按照这样的推测,显然美国的日新增病例还没有达到50万的程度,但是按照美国目前感染态势来看,即使在4月底,美国的新增感染人数都有可能突破100万。

按照美国总统以及美国疾病预防中心所做的推测,美国的新型冠状病毒感染的死亡人数很有可能会在10万到20万以上,因为这是美国总统最乐观的估计。而更为严重的估计是美国死亡人口可能会达到100万,而美国的感染人数将会超过1.5亿。对于这样的推测,显然是给美国社会带来了沉重的打压,毕竟这种状态也意味着美国将会消灭掉很大一部分老年人。新型冠状病毒致死率最高的就是60岁以上的老人,其致死率高达90%。而美国社会当中人口老龄化的比例达到16%,而这也意味着美国将会因此而消灭那些抵抗能力较弱,并且伴有多种老年病的老年人。

如今来看美国的确诊人数虽然较之前的三天有所减少,但是这也没有必要值得怀疑,因为感染人数在一定范围内出现波动,这是很正常的。被美国前期对疫情进行了全封闭的管控,那么美国的新增感染人数才会逐渐出现下降的态势,这样才算美国见到了疫情控制的拐点。如今,美国感染人数虽然只有27000多例,是目前我们还看不到美国疫情出现拐点,毕竟美国所采取的封闭行动与韩国和意大利还是有一定的差距,而韩国早就出现了疫情控制拐点,而意大利这几天也已经出现了疫情上升缓慢的态势。

那么对于美国而言,显然感染人数下降是一件好事,如果美国真的能够出现感染人数不断降低的状态,那对于美国来说可真的是一件幸事。越来越多的感染人数只会加重美国本身就有限的医疗体系,甚至会导致美国的死亡人口进一步上升。那么对于美国而言,如今的感染人数降低到27000例,如果能在今后几天内感染人数,继续保持下降的态势,这对美国来说绝对是一个值得庆幸的期待。就怕美国的感染人数在下一个数字周期内还会出现反复甚至上升。(淡然小司原创,本文图片来源于网络!)
根据美国霍普金斯大学发布的统计数据,现在全球新型冠状病毒肺炎的确诊病例是126万例,而美国方面的确诊病例是335,524例,死亡人数是9562人,在一天之内增长了29,704人,新增死亡病例是1271例,现在美国的检测数量是非常大的,到目前为止,美国一共检测了167万人,不得不说美国的检测效率非常高。因为美国发明了一种仪器,能够在5分钟之内检测出新型冠状病毒,其实这个确诊人数完全是因为美国检测数量所导致的,在最初的时候,美国根本不免费检测,所以美国的确诊病例数目非常少。

现在美国疫情最严重的地区是纽约州,这个地区的病例累计确诊了12万,美国纽约州州长科莫表示,在过去的24小时,纽约州新增长的新型冠状病毒确诊病例是8327例,累计确诊病例是122,031例,死亡病例是594例。现在美国的50个州都已经进入了紧急状态,不得不说美国疫情仍处于高峰期。但是美国之前预测可能会死10万人,如果不控制的话,死亡人数可能达到220万。

但是在昨天的新闻发布会上,美国总统特朗普表示,之前的预判可能预测的过多了,在未来可能死不了那么多人,初步估计美国的死亡人数应该在4~5万左右,这主要原因是,这种病毒可能在美国人中存在很久,有些人自动获得了抗体,因为检测数量167万,确诊病例34万,这个比例是大的惊人。从某种程度上说,这种病毒已经在美国传播有一段时间,在去年大行性流感中死了2万人,而感染的人数是3500万,也就是说去年冬天那么冷的天气,美国的死亡率也没有那么高,所以根据目前的情况来看,在美国有很多人已经产生了所谓的群体免疫。

当然在某种程度上,这和各个国家的检测与否是有关系的,如果像美国之前的状态,那么这个疾病可能会导致很少的人死亡,因为新型冠状病毒特别的严重,但是所产生的并发症情况各不一样,如果把这些数据摊开来,那么人数可能会像美国之前一样规避掉。这也就能解释之前为什么美国只死了2万人,现在有可能会造成4~5万人死亡,因为其余的几万人可能是被报告于其他并发症所引起的死亡。
美国的确诊病例,累计达到了33.7万多宗,其百万人口感染数量也达到了1026宗,有个不被注意到的细节是,美国治愈率仅在5.2%,要知道从3月19日美国疫情开始高峰期开始,至今已经18天。

美国的情况最近两天出现了两个反常的数值,第一个数据是在5日美国的单日治愈病例达到了5100多宗,但到了6日,其单日治愈量又降低到了3000宗,整体治愈率也下降到了5.2%。
要知道,当前疫情仅次于美国的西班牙,其治愈率在27.4%左右。
美国第二个反常的数据就是,单日确诊量,5日美国单日确诊量达到了35000多宗,但6日的单日确诊病例则在26000多宗,大约比前一天少确诊了9000宗。
当然,当前疫情排名在第二位的西班牙,6日的单日确诊量也只是6000宗,所以减少的这9000数值,实际上对疫情的走向还是非常关键的。

美国的疫情是从4月1日,也就是累计确诊量突破20万宗时,单日确诊量开始突破3万的,然后一直持续到了4月5日,现在降到了26000宗,似乎预算着美国疫情已经进入轨点。
实际上,美国之前的预测也是,大约在4月的第二个星期开始,疫情会进入峰值。
不过,虽然数据和之前的预测都说明单日确诊量降低到26000这个数值,很可能是美国情况的轨点到来,但从当前美国的实际情况来看,未必是这样。
美国虽然检测规模在不断提升,但其走的却是有症状检测机制,就是,只有出现症状,才会进行检测,而当前美国流感也仍然存在,二者症状也有很多类似的地方,所以这本身就促使美国的的筛选难度提升,以及一部分检测试剂用到了实际上是流感的群体中。
而美国这一检测试剂机制最大的弊端是无法排查出无症状感染者,而众所周知这一部分实际上也是占比非常大的一个基数。
韩国以及东亚进行的检测机制,主要是追踪和排查密切接触者机制,这本身就比美国采取的机制更能排查出无症状类型。

也就是说,美国全境实际上有一大批感染者还没有进行检测,就从现在已经累计确诊的数据中,也能推断出这一部分无症状者所占的数量。
实际上这也是为何美国治愈率(5.4%)明显低的原因。
这也是美国疫情仍然还颇为严峻的原因。
数据略有出入,美国昨天公布的数据显示,前天单日增加34970例,今天公布的昨天增加27827例,也就是说,美国从前天单日增长接近3.5万例,降到了2.7万多例,而不是2.6万例。
前天和昨天数据差别在7000多例,也就是降低了7000多例,是不是就可以了说美国疫情得到了控制,这也未必,疫情大爆发时期,数据增加减少太正常,前面美国的数据,也出现过降低几千例情况。包括昨天美国公布的治愈例一下子单日增加了5100例,而今天,只增加2000多一个道理,涨涨降降,太正常不过,说明不了什么问题,除非美国每天持续下降病例数,可能拐点就来了。

虽然美国数据昨天比前天降了一些,但以美国目前的疫情发展情况来看,不会持续下降,可能在短时期内,还会持续上升,因为美国前期遗留下来的问题太多,导致目前数据不断攀升。而美国民间群众对疫情的漠然态度,也必然导致疫情一时半会降不下来,还需持续发酵,或许,真如美国版钟南山预测的那样,疫情爆发,达到了几百万例,死亡大概十万到20万后,会有所下降。
一天两天的数据根本说明不了问题。
我们先看近期几天美国新增病例的变化值:
4月2日:新增31163例;
4月3日:新增30663例:
4月4日:新增34970例;
4月5日:新增27827例;
单从以上4天的新增病例数量来看,美国4月5日相对于前一天趋势病例新增直降近万人,但是个别一天的数据并不能说明问题,也不具有代表性。因为每天检测人数的多少直接导致这一数据是多一点还是少一点,之前有媒体披露的数据是美国单天检测人数约10万人,也就是说检测人数的30%大概就是一天的新增病例。但是4.4日当天出于某种原因(很有可能是检测试剂盒不够),检测放缓了,这也直接导致第二天新增人数减少。
从直降近万人的新增病例来看,美国的疫情“拐点”到了吗
所以说单看一天新增病例就判断美国疫情出现“拐点”是不科学的,况且新冠肺炎还有14-28天的潜伏期。
再者,现在美国的防控措施和居民的自我防护意识也并不到位,各地区娱乐场所依然对外开放,大街上还有很多不戴口罩出行的民众。特朗普甚至出于“将口罩留给医护人员”的出发点,建议民众“戴围脖”出门也是一样的效果,这与我国爆发疫情时,国家大力倡导“不戴口罩不出门”的政策是完全相悖的。

美国最终确诊的病例会有多少人
根据现在披露的数据,美国累计确诊病例已经达到31万之多,今天过后就极有可能突破33万人,相当于每1000个美国人中就有1个确诊。
假设现在包括实际确诊人数在内已有50-100万规模的人感染,那么根据新冠2-3的传染系数,再根据14天的潜伏期推算,未来2周内确诊人数就会激增到近300万级的规模,那么再过2周也就是5月初,这个规模很有可能突破千万级。

但是以上仅仅是在现行状态下基于数学模型的推理,影响这一趋势的还有很多因素,诸如更强的防疫措施、天气原因、未来可能出现的特效药和更佳的治疗方法等。
结语
从以上分析我们知道,一次数据并不能代表什么,未来美国还有很长的防控之路要走。基于全球一体化的出发点,我们也希望美国和全球的疫情都能尽快出现“拐点”,都能尽快过去,全球经济和贸易往来早日走上正规。
评论点赞,腰缠万贯;关注老刘,越来越牛。
大实话:这种事也没有必要造假什么的,这也是正常现象。
就特朗普之前的一些发言来看,其实现在美国的情况是要远比特朗普想象的要好很多的,之前特朗普说只要死亡人数在十万之内,那就是正常的。而之前特朗普又说了,自己之前可能太过于悲观了,就目前的情况来看,美国的最终死亡人数可能在五万左右。
这里请注意,人家说的是死亡人数,不是确诊人数,所以,在特朗普的美国标准下,现在的情况还很好,所以,自然是没有必要在这些新增确诊人数方面造假什么的。毕竟,人家关注的是死亡人数,而不是确诊人数。

而根据美国的一些专家预测,现在美国的疫情还没有达到高峰期,预计的高峰期应该是在四月中旬到来,也就是说会在下周到来,而按照美国保准来看的话,那就意味着在四月中旬死亡的人数可能会达到一个比较高的水平。
至于这两天确诊人数每日新增是两万多,还是三万多,哪怕是十万多,其实都无所谓的。并且,人家还能解释说检测这么多,是因为人家的检测设备比较先进,效率比较高,而不是因为美国疫情有多严重,这同样是美国的标准。

因此,在这种以死亡人数作为疫情严重与否的判断标准下,每天的新增确诊是多少人,对于美国来说,人家也不在意,也就是我们这些每日境内新增为零的地方的人,会觉得这种一天几万人确诊很吓人。
并且,就从现实角度来说,你现在看着美国的每日新增稳居第一还有感觉吗?我想大部分人的感觉都是这很正常啊甚至都不会因为是两万,还是三万的新增确诊而有什么大的情绪上的波动。
可能说明天美国新增确诊为几千,或者十万的情况下,我们才会说一句,WC。但是,也就是仅仅局限于此,看完之后,可能三两分钟就不会再有什么感觉了。
因此,不管美国的数据是真的也好,假的也罢,对于我们而言,那就是好好做好我们自己份内的事情,做好接下来这段时间的个人保护工作,没事别往人多的地方去,上街购物带好口罩。在全球疫情没有彻底结束之前,不要轻心大意。
最后,也希望全世界的人民能够尽快度过这个劫难,以后共同爱护好我们的生态环境。
有理有据,实话实说,关注:大实话。让我们一起用理性的视角看世界。
如果是真的,一天之内的确诊病例就减少近万!真该为他们庆祝了。但这个数字不可能是真的,因为他们的检测、救治原则,就必然让更大量感染者不可能被检测,这是因为如果他们的能力足够,把该做检测的都做了,那个指数级扩大的病例,现在已经超饱和运转的医疗体系就更无能为力了,群体免疫政策已经悄然逐步开始!


解读这个问题,如果再把他们治愈病例数字结合起来,就更说明美国应对疫情的政策,发生了一个大变化,检测、确诊的门槛应该又提高了,而治愈的标准降低了。美国的确诊检测原则从开始以来,一直执行以患者拨打911求救电话在予以检测确诊,在病人症状反应观察病情,必须立即住院救治者才能收治,其余一律居家自行治疗养病,能够自愈的就不会给医院增加压力,不能自愈的病情恶化了再住院救治,费用自理。

在这种确诊救治原则下,那些处于潜伏期的感染者,当然不可能被检测!那些普通家庭无力缴纳医保的感染者,由于无力承担动辄十几万美元的医疗费,再加上不到重症状态也不被收治,索性就不去骚扰911了,这个群体的感染者也是个庞大的数字,这就已经在官方发布的数字之外,积累一个更庞大的感染者群体。

美国发布今天的疫情公报,在确诊病例大幅减少的同时,治愈病例的数字也大幅增长了9千多。这种情况的出现只有一种可能,求救者的确诊检测要求,被更高的确认检测标准挡在了门槛之外(确诊了也无力收治白白浪费了昂贵的试剂盒资源);住院治疗的患者被更低治愈的标准确定为治愈,他得提前出院,给更多的重症患者腾地方,减少死亡病例。

这两个标准的实施,毫无疑问的就会使美国的确诊病例数字大大降低,治愈病例的数字大幅增加,似乎还能让死亡病例数字降低下来。但是那些不被检测的感染者,很可能在被确诊之前死亡;不被收治的确诊病例轻症拖成重症,就变成了可能治愈也可能死亡的病例,医疗体系的压力,并不会因此减轻 ,相反还会有相当程度的加大,死亡病例不会减少,相反还会增加,但这已经不在新冠肺炎的确诊病例数字了。

而那个美国专家预测的一两亿人口被感染者政策下,新冠病毒感染给这么大一个群体人口留下的,永久不可逆的健康伤害,会使美国国民的整体健康水平成指数幅度的下降,未来可能连美军军队的兵源,劳动力资源都会有很大程度的匮乏,就业率就不再是政府头痛的问题了。

一天两天的数据不能说明问题。昨天我还看了央视的一个视频,就是在纽约,好多人都开着车,根据政府公布的检测点去检测,结果所谓的监测点人毛都没有,只有一些垃圾。
估计美国的检测盒经过这些天的大量消耗,也整的差不多了。像他这种已经大规模感染,病入膏肓的状态,不检测就是最好的数据拐点。

如果美国还是照正常甚至强化检测力度,新增确诊数据还是每天呈下降趋势,那才是恭喜他们疫情已经到了拐点的时候。
但是,这种拐点发生后最后趋于平稳,也不是一天两天,起码也得一个潜伏周期——14天以上。
所以根据一次两次数据的下滑来确定美国是否渡过了危机为时尚早。
即便照最乐观的估计,现在就出现拐点,逐步下降,最终感染人数也不会低于50万人。而且,到目前为止,还只有纽约州在认真面对、积极解决问题。还有三十多个州马照跑舞照跳,一片歌舞升平的样子。

这些州到底是在蔓延还是在蔓延?相信新冠病毒不会因为谁表现的比较自信乐观就为其网开一面。
所以,根据我的观察,美国的情况一定不会太乐观。即便按照他们自己的预估,也得感染几百万人才对得起特大统领的漫不经心。
